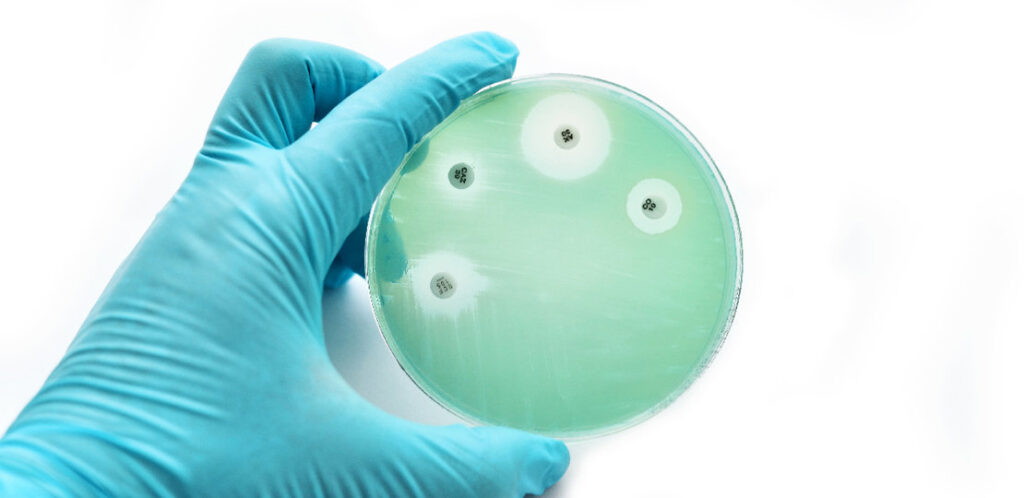
antimicrobianos

A tomada de decisão frente a um paciente com uma possível infecção é um dos momentos mais desafiadores na rotina médica. A pressão por acertar a conduta é imensa. Neste contexto, apresentamos o Guia de Antimicrobianos do Afya Whitebook!
Você entenderá, de forma clara, que este guia vai muito além de uma simples lista de antimicrobianos. Trata-se de um sistema de apoio clínico dinâmico, projetado para auxiliar o médico na escolha do agente antimicrobiano mais adequado, considerando:
- Sítio de infecção.
- Perfil do paciente.
- Padrões de sensibilidade local.
- Protocolos de tratamento mais recentes.
A importância desse instrumento é fundamental para a promoção do uso racional de antimicrobianos. A prescrição precisa evita tanto a subdosagem quanto o espectro excessivamente amplo, freando o avanço da resistência bacteriana.
Ao orientar condutas mais direcionadas desde o primeiro momento, o guia se torna um pilar na luta para preservar a eficácia dos antimicrobianos que temos hoje, assegurando que continuem salvando vidas no futuro.
Nosso objetivo, portanto, é proporcionar uma visão prática e aplicável do guia de antimicrobianos.
Abordaremos como acessar e interpretar as informações do guia de maneira ágil, simulando cenários clínicos comuns no pronto-socorro, na enfermaria e no ambulatório. Vem conhecer mais com a gente?
Como usar o Guia de Antimicrobianos no Afya Whitebook?
Para acessar o Guia de Antimicrobianos do Afya Whitebook, siga os passos a seguir:
- Abra o app do Afya Whitebook no seu celular ou navegador e faça seu cadastro.
- Faça login.
- Na página inicial, desça até a seção “Clínica e Especialidade”.
- Expanda o menu.
- Lá, você encontrará o Guia de Antimicrobianos. Toque nele para acessar.
Como encontrar conteúdos no Guia de Antimicrobianos?
Assim que abrir o Afya Whitebook, você já encontrará uma lista, categorizada por tipos diferentes de infecções, como nos exemplos abaixo:
- Infecções cardiovasculares.
- Infecções gineco-obstétricas.
- Infecções de cabeça e pescoço.
- Infecções de pele e tecidos moles.
- Infecções de VAS.
Você também pode aproveitar a barra superior para buscar pela condição específica que gostaria de saber mais, usando termos como:
- Abscesso peritonsilar.
- Encefalite viral.
- Toxoplasmose.
Ao acessar cada conteúdo, você terá informações completas sobre ele.
O que você encontra em um conteúdo do Guia de Antimicrobianos?
Conseguir usar o guia de antimicrobianos é muito simples, como você viu acima. Mas quais conteúdos estão disponíveis em cada item do guia?
Você pode encontrar as seguintes orientações médicas e conteúdo de apoio:
- Definição da infecção.
- Quais são os principais agentes da infecção.
- Respectivo tratamento empírico e hospitalar.
- Variações de tratamento para idosos, gestantes e crianças.
- Guias para abordagem completa da infecção.
- Guia de prescrição.
- Como identificar infecção em exames de imagem.
- Autoria e referências bibliográficas.
Ao trazer um conteúdo completo com base em evidências científicas, o guia te auxilia na identificação e prescrição correta dos antimicrobianos, oferecendo suporte e tirando dúvidas, de forma a te ajudar na decisão médica ao tratar um paciente.
Além do auxílio na tomada de decisão correta para um tratamento bem-sucedido e prevenção do aumento da resistência bacteriana no organismo, tornando o processo mais eficiente e otimizado para o bem-estar dos pacientes que atende.
Quer ir além da teoria e ver na prática como o guia de antimicrobianos auxilia em casos reais?
Teste você mesmo e comprove a agilidade para decisões mais seguras. Faça seu cadastro agora e tenha acesso imediato ao Afya Whitebook!